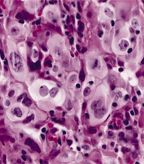

A new phase III trial found that first-line erlotinib followed by chemotherapy at disease progression to be significantly inferior to the standard practice of first-line cisplatin-gemcitabine followed by erlotinib.
Phase II studies have suggested that the EGFR tyrosine kinase inhibitor erlotinib (Tarceva) could be effective as a first-line therapy for patients with advanced non–small-lung cancer (NSCLC). A new phase III trial, however, found first-line erlotinib followed by chemotherapy at disease progression to be significantly inferior to the standard practice of first-line cisplatin/gemcitabine followed by erlotinib.
Large cell carcinoma of the lung
In one earlier phase II trial, erlotinib alone yielded a 23% response rate with 53% nonprogression after 6 weeks and a mean overall survival of 13 months. In another trial of elderly patients, the median overall survival was 11 months. Thus, researchers led by Cesare Gridelli, MD, of San Giuseppe Moscati Hospital in Avellino, Italy, initiated the phase III TORCH (Tarceva or Chemotherapy) trial, testing erlotinib as a first-line treatment for advanced NSCLC. The results were published in the August 20 issue of the Journal of Clinical Oncology.
Though recent research has made careful selection of patients for EGFR-TKI therapy possible, when the trial was initiated some controversy remained; thus, TORCH included 760 unselected patients, of 900 planned, due to early termination of the trial. A total of 612 patients were in Italy, and the other 148 were in Canada.
The early termination came after a planned interim analysis showed inferiority with the erlotinib first-line treatment. After a median follow-up of 24.3 months, there were 273 deaths in the erlotinib-first group and 263 in the chemotherapy-first group. The median survival was 8.7 months and 11.6 months, respectively, which yielded an adjusted hazard ratio of death in the erlotinib-first group of 1.24 (95% CI, 1.04–1.47).
Progression-free survival was also inferior in the erlotinib-first group, at 6.4 months vs 8.9 months for the chemotherapy-first patients, for a HR for progression of 1.21 (95% CI, 1.04–1.42). The objective response rate was also significantly worse in the erlotinib-first group (P < .001). Hematologic toxicities were more common and more severe among the chemotherapy-first patients, as were other adverse events including allergy, nausea, hair loss, and others.
“This result, of course, doe not negate that erlotinib can be beneficial for unselected patients pretreated with chemotherapy,” the authors wrote. And furthermore, first-line erlotinib has been found to be effective in carefully selected patients with EGFR mutation–positive tumors; notably though, it remains unclear if improvements in progression-free survival translate into overall survival benefit as well.
The median age of patients in the TORCH study was 62 years, and 33.7% of patients were female. Most patients were white, 20.7% had no history of smoking, and 55% had adenocarcinomas. EGFR mutation status was known in only 275 patients (36.2%); of those, 39 (14.2%) were EGFR mutation–positive, with 20 in the chemotherapy-first arm and 19 in the erlotinib-first group.